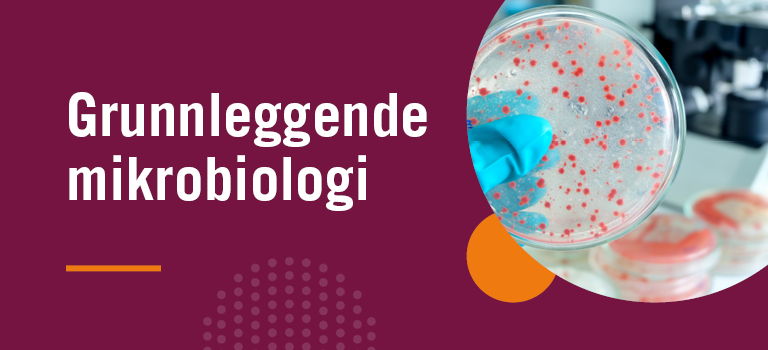
Grunnleggende mikrobiologi

E-læringskurs som gjør krav og ansvar forståelige i praksis
Søke
Søke >>
Sammensatte kurspakker
Våre kurs
For ansatte i restaurant og storkjøkken
English e-Learning Courses
Bedriftsløsninger
Sørg for effektiv opplæring av alle ansatte. Vi sammenstiller kurspakker tilpasset virksomhetens behov og ansattes roller.
Bedriftsløsninger →